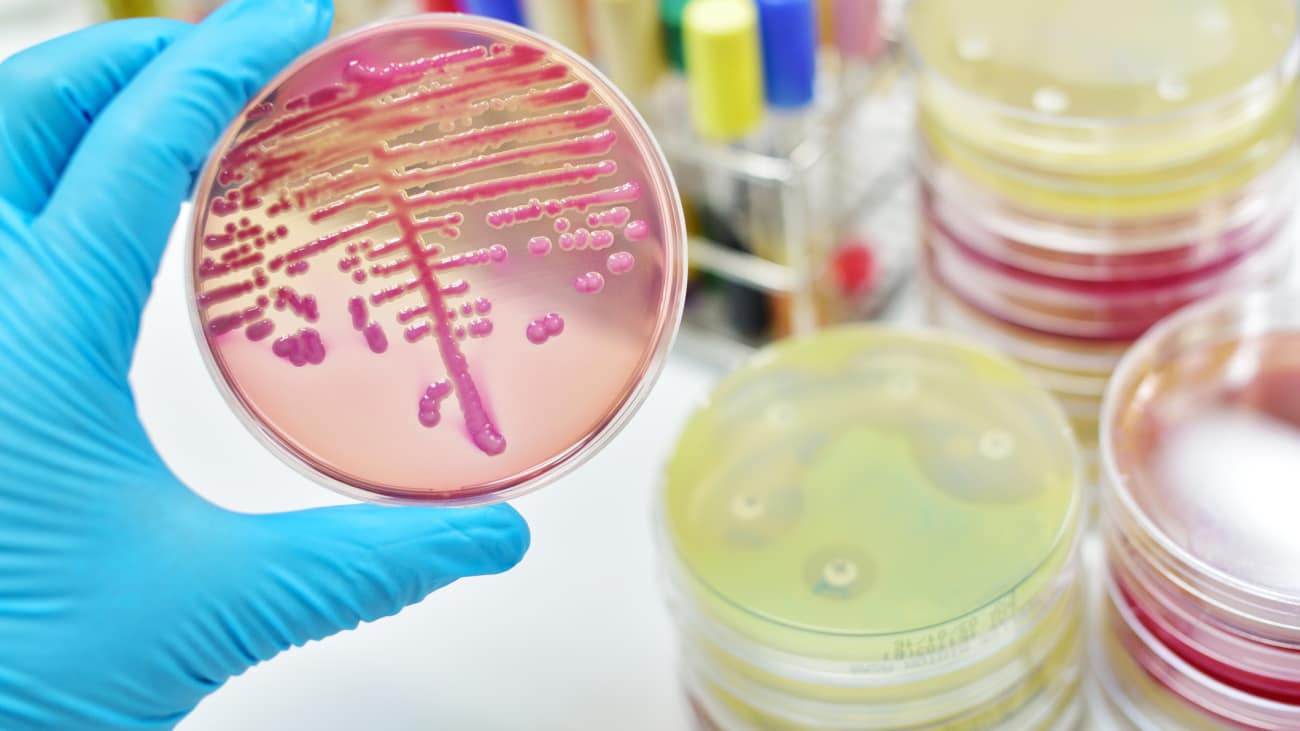

Treatment of Severe Infection
David Eschenbach, MD, reviews the pathophysiology and treatment of sepsis and identifies the toxin-producing bacteria least likely to respond to antibiotics. He explains how to identify the clinical features of a serious maternal infection and discusses treatment options.
Related Presenters
David A. Eschenbach, M.D. is a professor and chair of the Department of Obstetrics and Gynecology. Dr. Eschenbach received his medical doctorate degree from the University of Wisconsin and completed both a residency in obstetrics and ...